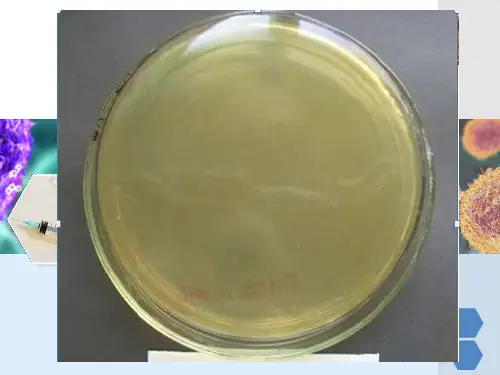

冀少版初中七年级下册生物:免疫
- 格式:ppt
- 大小:8.85 MB
- 文档页数:51




免疫-冀少儿版七年级生物下册教案一、教学目标1.了解什么是免疫系统,它的作用和重要性;2.掌握免疫系统的基本组成和机制;3.能够简单地描述机体的两种免疫反应:先天免疫和后天免疫;4.理解免疫系统在维持人体健康中的重要作用。
二、教学内容1. 免疫系统的作用和重要性讲解要点1.什么是免疫系统;2.免疫系统的重要性;3.如何维持免疫系统的健康。
讲解内容免疫系统是人体内的一个防御系统,作用是保护身体不受外部病菌的侵袭。
它包括了很多器官、组织和细胞,如淋巴结、脾脏、骨髓、白细胞等等。
免疫系统的重要性在于它可以帮助我们抵御病毒、细菌等外界入侵身体的病原体,保护我们的健康。
免疫系统的健康很重要,因为它对我们的健康和生命起着至关重要的作用。
通过锻炼身体和保持健康饮食,我们可以帮助免疫系统更好地工作。
2. 免疫系统的组成和机制讲解要点1.免疫系统的三个层次;2.免疫反应的机制;3.免疫系统在身体中的作用。
讲解内容免疫系统可以分为三个层次:第一层是防御系统,包括了皮肤、黏膜等组织,可以阻挡外界的入侵;第二层是先天免疫系统,通过吞噬、分泌以及炎症等方式来攻击病原体;第三层是后天免疫系统,通过免疫细胞的识别和记忆,来攻击入侵身体的病原体。
免疫反应的机制可以分为两种:非特异性和特异性。
非特异性免疫反应是指免疫系统通过一些非特定的方式来攻击入侵身体的病原体,如吞噬、分泌炎症介质等;而特异性免疫反应是指免疫系统能够识别并攻击特定的病原体,例如对于细菌、病毒等病原体的攻击。
免疫系统在身体中的作用非常广泛,它主要可以保护身体免受细菌、病毒等病原体的侵入,同时也可以帮助身体恢复健康。
3. 先天免疫和后天免疫讲解要点1.先天免疫的机制和特点;2.后天免疫的机制和特点;3.先天免疫和后天免疫的区别和联系。
讲解内容先天免疫是指人体天生就具备的抗病元素,通过直接或间接地攻击入侵人体的病原体来保护身体健康。
先天免疫可以通过吞噬、分泌炎症介质等方式来攻击病原体,同时和后天免疫之间也存在着交互作用。

冀少版七年级生物下册第六章第一节《免疫》教案及板书设计
一、非特异性免疫
【教学目标】
1.能够了解人体的前两道免疫防线是什么。
2.能够描述人体免疫功能,说明什么是非特异性免疫。
【教学重点】
理解人体非特异性免疫及其作用。
【教学难点】
理解人体非特异性免疫及其作用
【教学准备】
1.教师准备:
PPT课件、视频、图片
2.学生准备:
课前预习
【教学内容】
第一节免疫
二、特异型免疫
【教学目标】
1.能够描述人体的第三道免疫防线的免疫功能,区别人体的特异性免疫和非特异性免疫。
2.能够说明计划免疫及其意义。
【教学重点】
特异性免疫和免疫概念。
【教学难点】
特异性免疫和免疫概念。
【教学准备】
1.教师准备:
PPT课件、视频、图片。
2.学生准备:
课前预习。
【教学过程】
【教学点评】
本节的内容通过贴近生活的事例、丰富的动画、形象的比喻,深入浅出让学生感知了免疫的有关知识。
这个内容不是教师直接表达的,而是通过提供丰富的资料,学生通过分析得出的结论,还有一些部分也充分地运用了教材的资源,形式多样。

冀少儿版七年级生物下册《免疫》评课稿一、课程背景与意义《免疫》是冀少儿版七年级生物下册的一篇重要的教材内容。
通过学习这篇内容,学生可以了解到人体的免疫系统是如何保护我们的身体免受疾病侵害的,培养他们正确的健康观念和良好的个人卫生习惯。
同时,通过学习免疫系统的知识,学生可以增强对免疫技术和疫苗的认识,培养他们的科学素养和创新意识。
二、课程目标1.知识目标:–了解人体的免疫系统是如何发挥作用的;–掌握基本的免疫概念,如抗体、抗原等;–了解疫苗的原理及其在疾病预防中的作用;–了解免疫系统与个人卫生习惯的关系。
2.能力目标:–学会正确辨别病原微生物和自身细胞;–培养免疫观念,提高个人卫生习惯;–培养科学思维和创新意识。
三、教学内容与方法1. 教学内容本节课主要分为以下几个部分:•免疫系统的定义和作用;•免疫系统的组成和功能;•免疫系统对抗病原体的过程;•疫苗的原理及其作用。
本节课将采用多种教学方法,包括:•情景教学:通过故事、例子等方式,引发学生的兴趣,加深对免疫系统的理解;•合作学习:让学生分组合作,通过小组探究的方式,解决免疫系统相关问题;•实践操作:通过实验或模拟实验的方式,让学生亲自参与,体验免疫系统的工作过程。
四、教学流程1. 导入环节通过提问的方式,引发学生对免疫系统的思考:•你曾经感冒过吗?为什么感冒后会好起来?•看过医生给你打针的时候,有没有想过为什么要打疫苗?2. 知识讲解通过PPT和口头讲解,介绍免疫系统的定义和作用,以及其组成和功能。
•免疫系统是人体内一组复杂的细胞、器官和组织,负责保护我们免受疾病的侵害。
•免疫系统由淋巴器官、淋巴细胞和免疫分子等组成,它们协同工作,对抗病原微生物。
•免疫系统通过识别、攻击和消灭病原微生物,保护我们的身体健康。
通过故事情节、图片或视频等形式,展示免疫系统与病原微生物的对抗过程,激发学生的兴趣和学习动力。
•以我们身体的防线为故事主线,通过描述病原微生物入侵和免疫系统的反应,让学生更加生动地理解免疫系统的工作原理。
